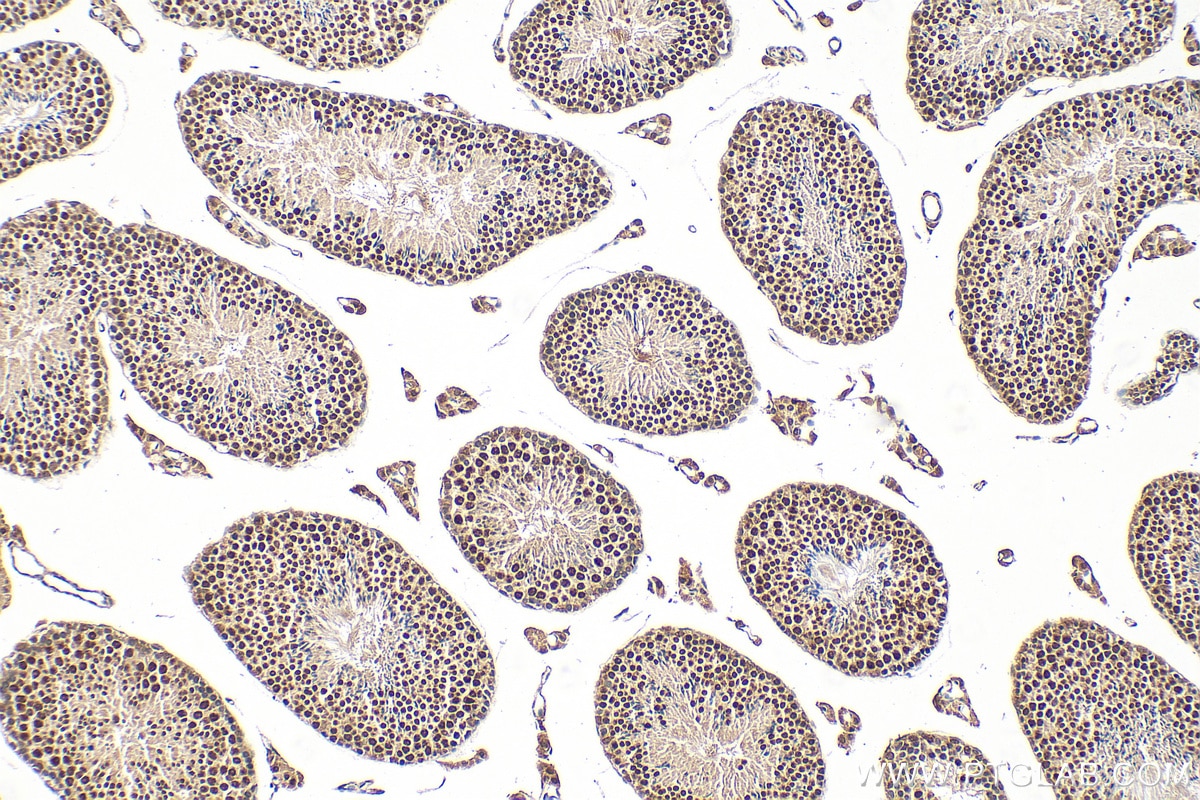
Immunohistochemical analysis of paraffin-embedded mouse testis tissue slide using 20175-1-AP (NCOA5 antibody) at dilution of 1:400 (under 10x lens). Heat mediated antigen retrieval with Tris-EDTA buffer (pH 9.0). Immunohistochemistry (IHC) staining of mouse testis tissue using NCOA5 Polyclonal antibody (20175-1-AP)

Validation Data Gallery
Tested Applications
| Positive WB detected in | HEK-293 cells, HeLa cells |
| Positive IP detected in | HEK-293 cells |
| Positive IHC detected in | human stomach tissue, mouse testis tissue Note: suggested antigen retrieval with TE buffer pH 9.0; (*) Alternatively, antigen retrieval may be performed with citrate buffer pH 6.0 |
| Positive IF/ICC detected in | A431 cells |
| Positive FC (Intra) detected in | HEK-293 cells |
Recommended dilution
| Application | Dilution |
|---|---|
| Western Blot (WB) | WB : 1:1000-1:4000 |
| Immunoprecipitation (IP) | IP : 0.5-4.0 ug for 1.0-3.0 mg of total protein lysate |
| Immunohistochemistry (IHC) | IHC : 1:200-1:800 |
| Immunofluorescence (IF)/ICC | IF/ICC : 1:50-1:500 |
| Flow Cytometry (FC) (INTRA) | FC (INTRA) : 0.25 ug per 10^6 cells in a 100 µl suspension |
| It is recommended that this reagent should be titrated in each testing system to obtain optimal results. | |
| Sample-dependent, Check data in validation data gallery. | |
Published Applications
| KD/KO | See 2 publications below |
| WB | See 2 publications below |
| IHC | See 1 publications below |
| IF | See 2 publications below |
| ChIP | See 1 publications below |
Product Information
20175-1-AP targets NCOA5 in WB, IHC, IF/ICC, FC (Intra), IP, ChIP, ELISA applications and shows reactivity with human, mouse samples.
| Tested Reactivity | human, mouse |
| Cited Reactivity | human, mouse, bovine |
| Host / Isotype | Rabbit / IgG |
| Class | Polyclonal |
| Type | Antibody |
| Immunogen |
CatNo: Ag14014 Product name: Recombinant human NCOA5 protein Source: e coli.-derived, PGEX-4T Tag: GST Domain: 112-384 aa of BC056872 Sequence: DMRDSRDPMYRREGSYDRYLRMDDYCRRKDDSYFDRYRDSFDGRGPPGPESQSRAKERLKREERRREELYRQYFEEIQRRFDAERPVDCSVIVVNKQTKDYAESVGRKVRDLGMVVDLIFLNTEVSLSQALEDVSRGGSPFAIVITQQHQIHRSCTVNIMFGTPQEHRNMPQADAMVLVARNYERYKNECREKEREEIARQAAKMADEAILQERERGGPEEGVRGGHPPAIQSLINLLADNRYLTAEETDKIINYLRERKERLMRSSTDSLPG 相同性解析による交差性が予測される生物種 |
| Full Name | nuclear receptor coactivator 5 |
| Calculated molecular weight | 579 aa, 66 kDa |
| Observed molecular weight | 66 kDa |
| GenBank accession number | BC056872 |
| Gene Symbol | NCOA5 |
| Gene ID (NCBI) | 57727 |
| RRID | AB_10694674 |
| Conjugate | Unconjugated |
| Form | |
| Form | Liquid |
| Purification Method | Antigen affinity purification |
| UNIPROT ID | Q9HCD5 |
| Storage Buffer | PBS with 0.02% sodium azide and 50% glycerol{{ptg:BufferTemp}}7.3 |
| Storage Conditions | Store at -20°C. Stable for one year after shipment. Aliquoting is unnecessary for -20oC storage. |
Background Information
Nuclear receptor coactivator 5 (NCOA5), also known as coactivator independent of AF-2 (CIA), possesses both repressor and activator functions (PMID: 11113208). It can interact with Estrogen Receptor (ER) alpha and ER beta in a ligand-dependent manner. NCOA5 has been shown to regulate the ER alpha-mediated transcription as well as the expression of the c-Myc gene (PMID: 11113208; 15073177). Recently identified as a conserved component of pluripotent stem cells, mammalian NCOA5 may contribute to the maintenance of the pluripotent stem cell population (PMID: 24268775).
Protocols
| Product Specific Protocols | |
|---|---|
| FC protocol for NCOA5 antibody 20175-1-AP | Download protocol |
| IF protocol for NCOA5 antibody 20175-1-AP | Download protocol |
| IHC protocol for NCOA5 antibody 20175-1-AP | Download protocol |
| IP protocol for NCOA5 antibody 20175-1-AP | Download protocol |
| WB protocol for NCOA5 antibody 20175-1-AP | Download protocol |
| Standard Protocols | |
|---|---|
| Click here to view our Standard Protocols |
Publications
| Species | Application | Title |
|---|---|---|
Cell Rep SILAC Proteomics of Planarians Identifies Ncoa5 as a Conserved Component of Pluripotent Stem Cells. | ||
Biochem Biophys Res Commun NCOA5 is a master regulator of amino acid-induced mTOR activation and β-casein synthesis in bovine mammary epithelial cells.
| ||
Cell Death Discov NCOA5 induces sorafenib resistance in hepatocellular carcinoma by inhibiting ferroptosis
|